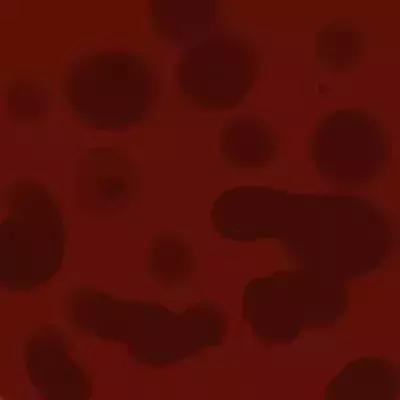
恶露少说明子宫恢复不好吗,产后子宫恶露没排净怎么办

对于产后的妈妈而言,产后身体都会有一些变化:乳房慢慢胀大、开始有奶水、产后盆骨的骨架也会变大、臀围变粗,而产后恶露也算是产后身体变化的重要一环。
子宫产后恢复的好不好看看恶露情况是否正常便能知晓。但要注意的是,在观察恶露的时候要看颜色、气味的变化和质与量的多少,才能看出子宫恢复的快慢。
产后恶露是什么?
产后恶露是指随子宫蜕膜脱落,含有血液分泌物经阴道排出,称为恶露,是产妇在产褥期的生理性变化。
这是产后妈妈在产褥期常见的临床表现,属于生理性变化。

产后恶露哪些情况算正常?
一般来说,产妇可以观察恶露的颜色来判断子宫的恢复有无异常,正常的恶露应是这三种形态:
血性恶露
通常会持续3-4天,因为含有较多的血液,所以颜色呈红色或暗红色,量也比较多,大概与平时月经量一般,或稍多于月经量,有时还带有血块,有血腥味。这是正常的现象,产妇无需过于担心。
浆液性恶露
浆液性恶露呈淡红色,其中含有少量血液、粘液和较多的阴道分泌物,这是由于细菌生长,味道会比较重,大概持续10天,是属于正常的范围。

白色恶露
主要含有大量白细胞,颜色较白,质地略粘稠,性状近似白带,这个持续3周左右。

产后恶露要多久才能排干净?
顺产妈妈可能恶露会持续2-4周,时间较长。
剖腹产妈妈可能在7-10天就没有了,整体恶露量较少。
不过也会有少数妈妈产后长时间恶露不止,如果产后恶露超过6周(42天)以上还没有排干净的话,就需要马上就医了。

哪些情况需要看医生?
在恶露排出期间,妈妈们要注意观察恶露排出的量以及外观颜色是否有异常,如果出现了不良恶露,需尽快联系医生:
1.护垫更换太频繁
正常的恶露在产后一天之内,流量会达到最多,建议1小时就可以更换一次护垫,若以此频率替换,其实恶露量大约只占护垫三分之一到二分之一的面积。不过,如果在1小时之内,恶露几乎沾满整块护垫,且须更换2~3次以上,或是流量超过500毫升。妈咪就要主动向医生反应,因为这有可能是产后大出血的征兆。
2.恶露伴随异味
血块其实是培养细菌的温床。如果生产之后,血块及胎膜组织没有尽速排出体内,反而继续堆积在子宫内,就会引起细菌感染,使恶露产生恶臭味。
3.下腹疼痛或发烧
有些产后妈咪会因为子宫内膜发炎而引起发烧现象,也就是俗称的产褥热。医生指出,孕妇在生产的时候,若破水太久,很容易造成子宫感染。一旦子宫遭受感染,除了会使恶露变成深红色及产生恶臭之外,产妇还会出现发烧或下腹疼痛等现象。
产后恶露期如何护理?
注意清洁卫生
月子里清洁身体,建议采取淋浴的方法,不要盆浴或坐浴,以免*处私**伤口感染。
按摩帮助恶露排出
顺产的妈妈可以以画圈圈的方式来按摩腹部子宫位置,让恶露顺利排出,而剖宫产的妈妈因为有伤口则不能做这一动作。
母乳喂养
宝宝的吸吮在刺激催乳素产生的同时,还会促进缩宫素的产生,使子宫收缩,有助于恶露排出。

总的来说,产后恶露是产妇生产后的一种自然生理变化。但由于恶露的症状表现各有不同,在产褥期还需要认真观察恶露的变化,正确的护理,才能保证宝妈顺利地度过这个阶段哦。